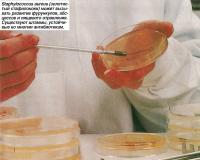

| Название картинки: | Делийский фурункул - разновидность кожного лейшманиоза |
| Ширина и высота: | 434 x 358 точек |
| Размер файла: | 34 834 байт |
| Дата добавления: | 2 Апреля 2017 |
| Ссылка на картинку: | deliyskiy-furunkul-raznovidnost-kozhnogo-leyshmanioza.jpg |
| Статья расположения: | Энциклопедия медицинских терминов на букву D (англ.) |
| Если вы хотите вставить эту картинку на сайт или форум разместите этот код: HTMLBB CodeText
| |